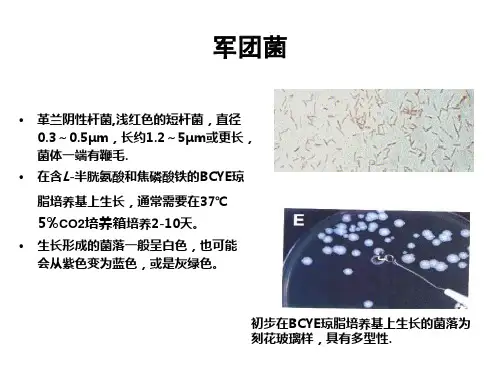

军团菌的分离培养与鉴定
- 格式:ppt
- 大小:4.79 MB
- 文档页数:63


军团菌检验方法实施细则1适用范围:本细则适用于各类样品中军团菌的检测鉴定。
2检测依据:国家《传染病诊断标准》WS195-2001 军团病诊断标准及处理原则军团病诊断标准及处理原则,卫生部,2002年上海市卫生防疫站1979;卫生防疫细菌检验,第一版,上海科技出版社3设备与材料3.1冰箱:4~-20℃。
3.2恒温培养箱:36±1℃。
3.3振荡器3.4显微镜40x 100x3.5离心机12000rpm3.6架盘药物天平:0 g -500g, 精度0.5g。
3.7锥形瓶:100 mL、500 mL。
3.8灭菌吸管:1mL (具0.01mL刻度)、10mL (具0.1mL刻度)。
3.9灭菌平皿:直径90 mm。
3.10灭菌试管:16 mm×160 mm.。
一般用的是18*180mm3.11 温水浴箱:36±1℃3.12 二氧化碳培养箱:5%CO236±1℃3.13 紫外灯3.14 过滤器4培养基和试剂4.1 BCYEα琼脂成份:N-2-乙酰胺基-2-氨基乙烷磺酸(ACES) 10.00 克氢氧化钾片(85%KOH 试剂级) 2.80 克活性炭(Norit A) 1.50 克酵母浸膏(Difco) 10.00 克琼脂(Difco) 17.00 克α-酮戊二酸(单钾盐) 1.00 克L-半胱氨酸盐酸盐(溶于10毫升蒸馏水中) 0.40 克焦磷酸铁(溶于10毫升蒸馏水中) 0.25 克蒸馏水 1000 毫升4.2甘氨酸、万古霉素、多粘菌素B(GVP)琼脂成份:除上述每升BCYEα琼脂成份外,再加:甘氨酸 3.00 克万古霉素 5.00 毫克多粘菌素B 10 万单位4.3 明胶酶试验培养基:此培养基的制备,除用明胶(每100ml 中加3g )代替琼脂外,其它同BCYE α培养基。
4.4 酪氨酸BCYE α培养基:在BCYE α琼脂中除去碳粉,再于每升培养基中加0.45g 酪氨酸。

军团菌细菌分离鉴定作业指导书【方法】1、标本运送和保存:军团菌抵抗力较强,但仍需尽快送实验室,以防污染菌生长。
应避免反复冻融。
水样标本应尽可能快或最好2d内送到指定实验室,不必冷冻,但应避光和防止受热,室温下贮存不得超过15d。
收到水样后应尽快进行检测,尤其对于已知含有生物防腐剂的样品,最好采样当天检测。
2、形态观察革兰染色:幼龄菌为革兰阴性短小杆菌,培养数日后可见多形性和长丝状。
革兰染色还可见菌体有空泡。
鞭毛染色可见1—2根单鞭毛和侧鞭毛,无荚膜、无芽胞。
3、培养特性观察:将待检菌接种BCYE平板、F-G平板、血平板和巧克力(色)血平板上,须置37℃,2.5%二氧化碳,需氧高湿度环境下培养37天。
如果在48小时内出现菌落或在这些培养液上均生长,则不是军团菌,如果仅在BCYE或F-G平板上生长,另外两种平板上不生长,而且至少在72小时以后出现菌落,则可能是军团菌。
在BCYE平板上4—5天可形成针尖大小的菌落,继续培养数日后菌落直径可增大至4—5mm。
菌落灰白色、圆形、湿润、有光泽、边缘透明。
呈刻花玻璃样条纹为其特征。
菌落较为黏着,并有特有的酸臭味。
在紫外线可见表面呈现白色自发荧光。
在F-G平板上培养10天才见生长,并可产生棕色色素。
4、生化反应触酶、氧化酶、β-内酰胺酶及马尿酸水解实验均阳性,不分解糖类产酸、脲酶及硝酸盐还原实验阴性。
5、气相色谱显示军团菌的细胞脂肪酸组成,易与其他细菌区别。
6、血清学检查(1)微量凝集实验:首先将军团菌标准株接种于BCYE或其他专用培养液上,35℃2.5%二氧化碳,需氧高湿度环境下培养3—4天,用0.01mol/l、pH7.4磷酸盐缓冲液(PBS)洗下菌苔,沸水浴1小时杀菌。
2000rpm离心10分钟后弃去上清液。
用含0.5%福尔马林的磷酸盐缓冲液配成悬液,使其浓度在420nm波长,光径1cm时吸光度值为0.65,即为诊断菌液。
诊断菌液在用前加石炭酸复红液1ul。

军团菌检测方法军团菌概况军团菌是一种环境感染性致病菌,可引起急性呼吸道传染病,即军团菌病。
军团菌分布极其广泛,医院、酒店等的供水系统、空调的冷却系统等各种水源均易于滋生、污染军团菌,并造成军团菌病传染的风险。
即与水有关的地方均可能存在军团菌。
军团菌传播、感染有以下特点:1、透过空气、水份感染,传播带季节性,超过50%病例在夏季发生。
2、滋生在医院、酒店的供水系统,通过过水龙头、浴室传播。
3、可通过空调的冷却系统,由通风口传播并感染对象。
军团菌属革兰氏阴性杆菌,专性需氧,无芽孢,无荚膜,军团菌需要半胱氨酸和铁,无半胱氨酸时,军团菌无法生长。
生化特征还有不发酵也不氧化糖类,不还原硝酸盐,氧化酶实验阴性或弱阳性,尿素酶阴性,军团菌生长的最适pH为6.9-7.0,2%-5%CO2能促进部分菌株的生长。
军团菌生长缓慢,易于被其它菌落覆盖。
军团菌的菌落颜色多样,通常呈白色、灰色、蓝色或紫色,也能显深褐色、灰绿色、深红色。
菌落整齐,表面光滑,在紫外灯下,有荧光。
目前军团菌分为64种血清型及42个种。
ISO11731水样中军团菌检测方案采样:一般用玻璃或聚乙烯等无菌容器采样。
如果水样中含有消毒剂,需在采样前或采样后加入中和剂,含氯或氧化型消毒剂可用硫代硫酸钠或硫代硫酸钾作中和剂。
水样应当天检测为佳。
样品富集:如果样品中军团菌的数目预计多于105cfu/L,直接取样涂布于GVPC平板上分离培养检测。
如果样品中军团菌的数目未知或较少时,一般采用滤膜法或离心法富集军团菌。
滤膜法:将水样以0.22μm滤膜过滤浓缩,然后加入5ml无菌水,超声波振动混匀3min后为浓缩样品。
离心法:将水样置于高速离心机中,6000g离心15min,(15℃-25℃),弃去上清,然后加入2ml-10ml无菌水,混匀后为浓缩样品。
样品处理:将浓缩样品分三份,一份直接取样涂布于GVPC平板上分离培养。
一份酸处理:2ml浓缩液+2ml缓冲液(0.2mol/L的HCl 3.9ml+ 0.2mol/L的KCl 25ml,KOH溶液调pH2.0±0.2),摇匀5±0.5min。

军团菌分离注意事项军团菌是一类造成严重呼吸道感染的致病菌,对于分离和处理军团菌的工作,需要特别的注意和细心。
以下是对于军团菌分离的注意事项:1. 安全防护:军团菌分离工作需要在生物安全实验室进行,确保操作人员具备必要的安全防护意识和技能。
操作人员应穿戴防护服、手套、口罩和护目镜,避免直接接触军团菌,以防止交叉感染和意外事故发生。
2. 操作规范:对于军团菌的分离工作需要严格遵守操作规范,确保操作过程中无菌操作。
严禁在实验室内饮食、吸烟和喷嚏,避免菌液污染和环境污染。
3. 实验设备:在军团菌分离工作中,需要使用高质量的实验设备和试剂,确保实验条件和结果的准确性。
对于实验设备和试剂的选择和使用需要严格按照实验方案和要求进行,避免污染和误操作。
4. 样本采集:在进行军团菌分离工作之前,需要对样本进行采集和处理。
对于样本的采集需要严格按照操作规范进行,避免外界污染和样本损坏。
同时,对于采集的样本需要及时处理,避免样本存放时间过长导致污染和变质。
5. 分离增殖:在进行军团菌分离工作时,需要进行分离和增殖培养。
在培养过程中需要严格控制培养条件和培养时间,避免菌落数量过多或者过少影响后续的实验操作和结果判读。
6. 结果判读:对于军团菌分离后的结果,需要进行准确的判读和鉴定。
在判读和鉴定过程中需要参考相关文献和标准,确保分离结果的准确性和可靠性。
7. 废弃物处理:在军团菌分离工作结束后,需要对实验产生的废弃物进行正确的处置。
对于实验产生的废弃物需要进行消毒处理,确保废弃物不会对环境和人体造成危害。
总之,军团菌分离工作需要高度注意和细心操作,确保实验过程和结果的准确性和可靠性。
操作人员需要具备丰富的实验经验和严谨的工作态度,才能够完成军团菌分离工作并取得可靠的实验结果。


军团菌病诊断标准及处理原则
军团菌病是由军团菌属细菌引起的一种感染性疾病,主要通过呼吸道传播。
下面是关于军团菌病的诊断标准及处理原则:
一、诊断标准:
1. 临床症状:典型病例以肺炎为主要症状,表现为高热、咳嗽、胸痛等呼吸道感染症状。
2. 实验室检查:需要通过培养分离、鉴定军团菌属细菌来明确诊断。
3. 支原体试验:如军团菌属特异性抗原实验(LAT)、军团菌属特异性抗体滴度检测等。
二、处理原则:
1. 抗生素治疗:选择敏感的抗生素进行治疗,一般常用的有呋喃妥因、阿奇霉素等。
治疗时间一般为2-3周,严重病例可延
长治疗时间。
2. 高氧疗法:对严重的呼吸道感染症状,可以采用高氧疗法,以改善患者的氧合情况。
3. 支持疗法:如液体补充、退热、止咳等支持性治疗,以提供患者的基本生命支持。
特别需要注意的是,军团菌病是一种传染病,需要采取必要的防控措施,如隔离患者、消毒和清洁环境等,以防止病原体的进一步传播。
同时,也需要加强对患者的健康教育,提高个人防护意识,以预防军团菌病的发生。